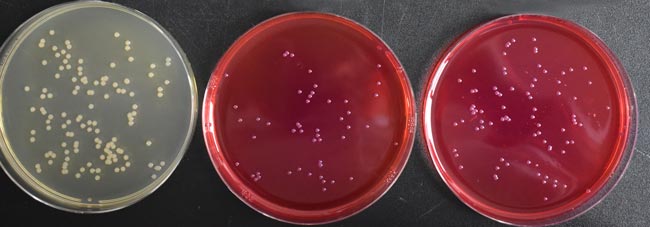

用途:用于药品中洋葱伯克霍尔德菌的选择性分离培养。
添加剂:
每瓶需配5盒HB9218a BCSA抑菌剂(1ml*5);
每200ml培养基添加1支HB9218a BCSA抑菌剂(1ml*5)。
成分(g/L)
Casein Peptone/胰蛋白胨
|
10.0
|
Sucrose/蔗糖
|
10.0
|
Yeast Extract/酵母提取物
|
1.5
|
Crystal Violet/结晶紫
|
0.002
|
Lactose/乳糖
|
10.0
|
Sodium Chloride/氯化钠
|
5.0
|
Phenol Red/酚红
|
0.08
|
Agar/琼脂
|
14.0
|
pH值6.8±0.3
|
25℃
|
用法:
称取本品50.6g,加热煮沸完全溶解于1000ml纯化水中,分装三角瓶,121℃高压灭菌15分钟,冷却至45℃~50℃时,每200ml培养基中加入1支BCSA抑菌剂(含庆大霉素2mg,万古霉素0.5mg,多粘菌素B120000U),混合均匀,倾入无菌平皿,备用。
洋葱伯克霍尔德菌选择性琼脂(BCSA)(USP标准)微生物质控结果:

洋葱伯克霍尔德菌 ATCC25416

洋葱伯克霍尔德菌 ATCC BAA-245
多噬伯克霍尔德氏菌 ATCC BAA-247
洋葱伯克霍尔德菌选择性琼脂(BCSA)(USP标准)微生物灵敏度试验:
按标签用法制备培养基,接种以下质控菌株,放置30-35℃需氧培养48-72小时。

标准依据:
USP42非无菌产品微生物测试—BCC洋葱伯克霍氏菌测试 点击下载


 海博微信公众号
海博微信公众号
 海博天猫旗舰店
海博天猫旗舰店


 海博微信公众号
海博微信公众号
 海博天猫旗舰店
海博天猫旗舰店






